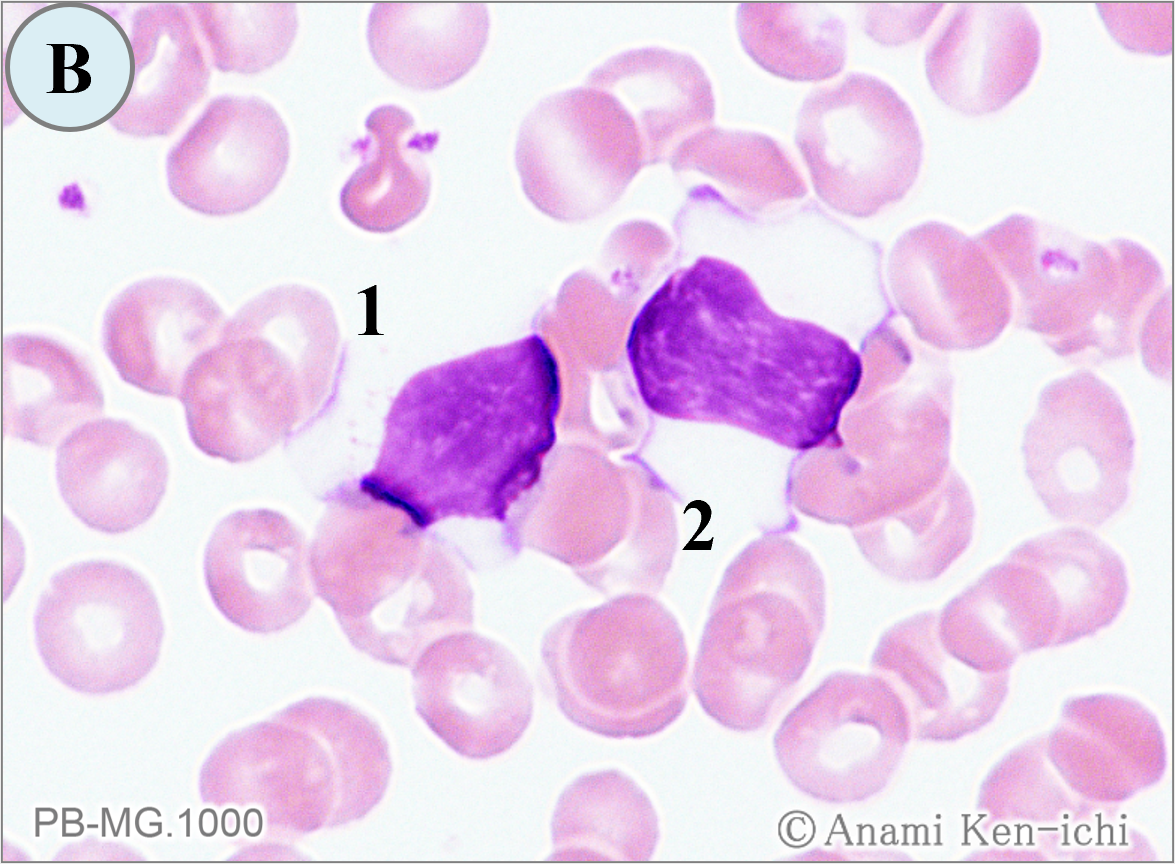
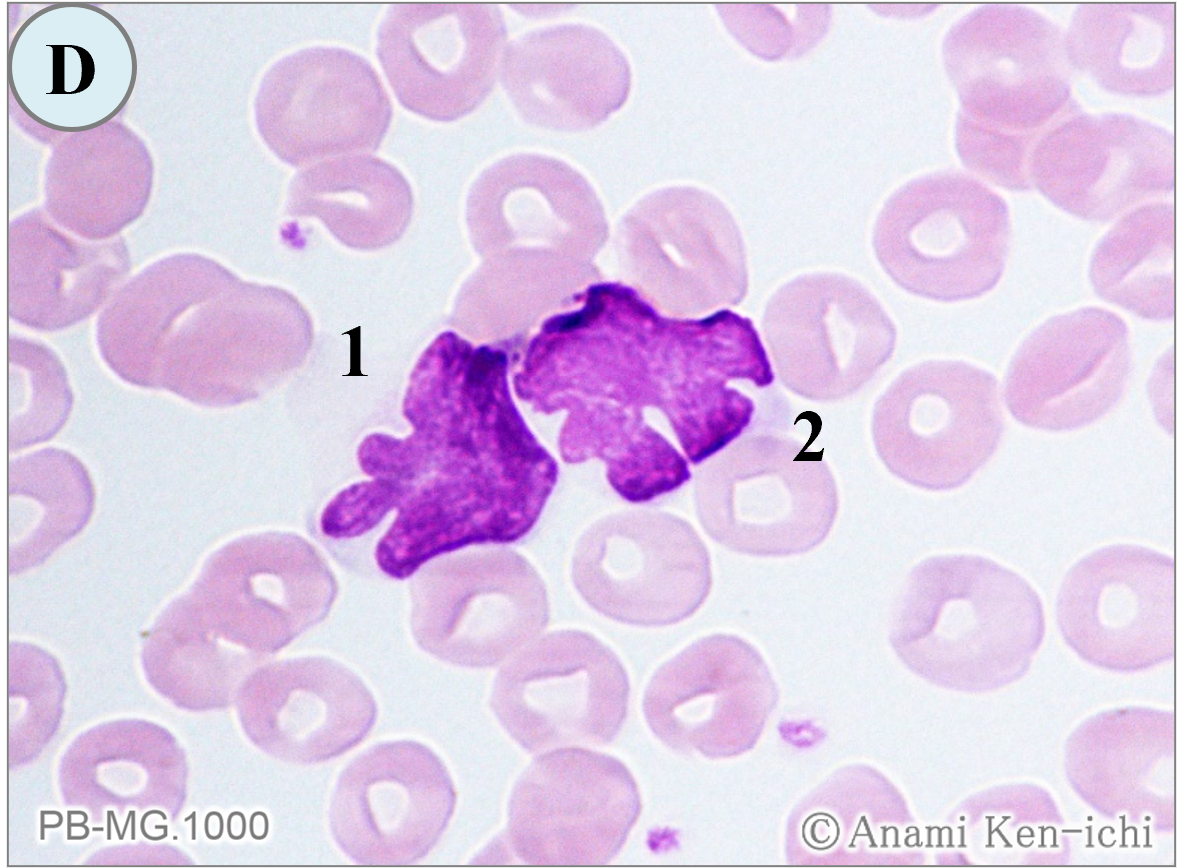

浄土宗は開宗850年を迎え、開祖である法然(ほうねん)の「法然と極楽浄土」の特別展が「九州国立博物館」(福岡県太宰府市)で開催されていると聞いて足を運びました(2025.11.19)。
時は平安時代末期、貴族から武士へ権力が移り、内乱、飢饉、災害など社会不安が広がるなか、人々は「末法の世」と感じ、来世の救済を願うようになりました。法然(1133~1212)は、どんな人も、阿弥陀仏を信じて“南無阿弥陀仏”と称えれば、すべての人が平等に極楽浄土に往生できると説きました。18歳頃、比叡山で天台宗の教学を学び、その頃、法然は「法然房源空(ほうねんぼうげんくう)」とよばれていましたが、弟子や信者さらに貴族層から支持を受けこれに敬称が加わり「法然上人」となりました。
当時の仏教界は南都北嶺と呼ばれる既存の巨大な勢力によって支配されていました。比叡山延暦寺(滋賀県)を中心とする最澄の天台宗、高野山(和歌山県)に開宗した空海の真言宗、また、新興の宗派として栄西を中心とする臨済宗、法然の弟子親鸞による浄土真宗など勢力争いは凄まじいものでした。旧仏教勢力の「自力」による修行で悟りを得る考えと、法然上人の「他力」による救済の教えは相容れないものでした。結局、旧仏教派からの圧力もあり、建永の法難(1207)、後鳥羽上皇によって、法然上人は土佐へ、親鸞聖人は越後へ流罪となりました。法然没後、弟子たちによって継承され、江戸時代には徳川家康公の帰依を受けて発展することになります。
今や世界の宗教は多岐にわたり、個人のアイデンティティの一部となっているようですが、日本では無宗派が多く、文化や伝統的な生活習慣として捉えられているようです。法然上人の説法が“南無阿弥陀仏”そして没が建暦2年(1212)1月25日とされますので、私の名前そして生年月日(12月12日)が被っているようで何かの縁を感じて心配しております。
法然上人の肖像画(知恩院/京都)
(展示場で購入したA4ファイル)
2025.11.19

法然の主著「選択(せんちゃく)本願念仏集」
2行目は法然の直筆ともいわれる
(A4ファイル)

2026年1月号の問題. 下記のご質問をいただきましたがどのようにお答えしますか。
| 【Q1】 | 鉄染色で陽性の顆粒が微細であっても、核周1/3以上かつ5個以上あれば環状鉄芽球と判定してもよいですか。鉄染色をうまく染めるコツをお願いします。 | |
| 【助言1】 | 鉄顆粒が微細であっても、核周囲の1/3以上かつ5個以上の定義を満たしていれば環状鉄芽球にカウントしています。鉄染色をうまく染めるコツは、用手法の場合、反応液の①2%フェロシアン化カリウム、②2%HCL、③1%サフラニンOを番号順に混合することで、それは濾過後使用します。また、従来から主流であった有害なホルマリン固定に代わり、安全性を考慮して、メタノール等のアルコール系固定液を採用する施設も増えているようです。 | |
| 【Q2】 | 赤芽球系前駆細胞あたりに発生する異常とそれに関連する血液疾患を教えてください。 | |
| 【助言2】 | 赤芽球系前駆細胞や分化・成熟過程の赤芽球に異常が生じると、産生能の低下、無効造血による成熟障害、あるいは破壊の亢進や赤血球寿命の短縮が引き起こされ、結果として貧血を呈します。造血幹細胞・多能性前駆細胞レベルの異常では、クローン性造血としてMDS、量的減少として再生不良性貧血、補体制御因子の欠損として発作性夜間血色素尿症が起こります。次に、赤芽球系前駆細胞レベルの異常では、選択的抑制・破壊として赤芽球癆、EPOの供給不足として腎性貧血が起こるとされます。 | |

2026年2月号の問題. 下記のご質問をいただきましたがどのようにお答えしますか。
| 【Q1】 | CMMLで血清リゾチームが上昇するとされますが、腫瘍性と反応性の単球増加では、リゾチーム値の上昇する程度に差はあるのでしょうか。 |
|
| 【Q2】 | 腫瘍性疾患において、LD、UA、可溶性IL-2Rが上昇するメカニズムを教えてください。 |
|

形態マガジン号キャプテン 阿南 建一

「細胞同定」は、骨髄のMG染色における鑑別を要する細胞に挑戦します。
「ワンポイントアドバイス」は、鉄染色における環状鉄芽球の判定と染色法の注意点、また、赤芽球系前駆細胞の段階で起こる病態について解説します。
問題1
PB-MG.1000

PB-MG.1000

PB-MG.1000

PB-MG.1000

問題
骨髄像の細胞同定を行ってください。
【解説】

A-1.2. 同系の細胞と考えます。
A-1. 直径19μm大、N/Cは低く、核は軽度不整形を示し、クロマチンは粗剛です。細胞質は弱いながらも部分的に好塩基性を認めます。
A-2. 直径17μm大、N/C比は低く、核は類円形、クロマチンは粗剛であり、細胞質には部分的に好塩基性を認めます。以上のことより、両者は異型リンパ球(反応性リンパ球)と判定しました。
B-1.2. 同系の細胞と考えます。大きさは直径15~16μm大で、N/C比は低いようです。
B-1. 核はほぼ円形で偏在しクロマチンは粗剛、細胞質は淡青色です。
B-2. 核は類円形で中央に位置し、クロマチンは粗剛で細胞質は淡青色のことから、両者は(大)リンパ球と判定しました。

C-1. 直径20μm大、N/C比は高く(核占80%以上)、核は類円形で核形不整や明瞭な核小体を認めクロマチンは網状、細胞質は軽度好塩基性のことから芽球を思わせます。ただ、N/C比が高く、核形不整や核小体そしてクロマチンが網状のことから腫瘍性芽球と判定しました。 本例は、低芽球比率のMDSの症例です。
D-1.2. 同系の細胞と考えます。大きさは15μm大です。両者とも、核形不整が顕著で花弁状を呈し、クロマチンは粗剛で濃染傾向です。細胞質の好塩基性は軽度で、核形の立体的な不整を認めることから、異常リンパ球(ATL細胞疑い)と判定しました。本例は、成人T細胞白血病(ATL)の症例です。リンパ球の核形不整は、採血後の経時的変化によっても起こるため、ATLを疑う場合は抗HTLV-Ⅰ抗体陽性の確認が必要です。
これから先のページでは、医療関係者の方々を対象に医療機器・体外診断薬等の製品に関する情報を提供しております。当社製品を適正に使用していただくことを目的としており、一部の情報では専門的な用語を使用しております。
一般の方への情報提供を目的としたものではありませんので、ご了承ください。
医療関係者の方は、次のページへお進みください。
(お手数ですが、「進む」ボタンのクリックをお願いします)